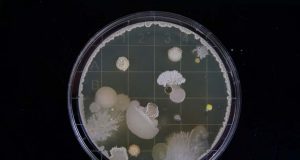

Menyebar Mikroba di Mars Sebagai Awal Kolonisasi
Apakah anda pernah membayangkan, seperti apa rupa penduduk pertama planet Mars nanti? Mungkin anda membayangkan mereka adalah orang-orang terbaik dan paling cemerlang yang ada...
Bukti Lain Menunjukkan Keberadaan Danau di Mars
Dengan menggunakan penjelajah Curiosity NASA, para peneliti sepertinya dapat memperkirakan seperti apa Mars sebelumnya. Berdasarkan data-data yang telah dikumpulkan, diperoleh sebuah bukti yang menunjukkan...
Ditemukan Sebuah Kota Berusia 5.000 Tahun di Israel
Sisa-sisa sebuah kota besar berusia 5.000 tahun telah ditemukan di Israel, memberikan petunjuk baru terhadap pemahaman para ahli tentang periode tersebut, menurut Otoritas Kepurbakalaan...
Darah Buatan Untuk Semua Golongan Berhasil Dikembangkan
Para peneliti dari Jepang telah berhasil mengembangkan darah buatan yang dapat ditransfusikan terhadap pasien yang membutuhkannya, terlepas dari jenis golongan apa darah mereka. Saat ini,...